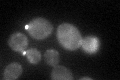
YLR114C
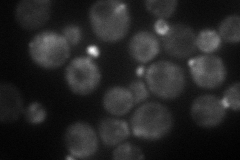
YLR114C
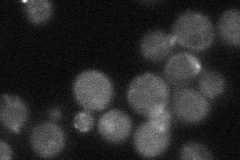
YLR114C

View description
Conserved protein involved in exocytic transport from the Golgi; mutation is synthetically lethal with apl2 vps1 double mutation; member of a protein superfamily with orthologs in diverse organisms
Localization:
Intensity:
Fold change:
Significance:
-
C’ GFP library in SD
cytosol, bud neck -
N' NOP1pr-GFP in SD

punctate,bud neck57.9707 -
N' TEF2pr-mCherry in SD
punctate,bud neck68.7695 -
N' NATIVEpr-GFP in SD
bud neck32.2181 -
N' TEF2pr-VC and Cyto-VN in SD

bud neck44.7433 -
C’ GFP library in SD+DTT

cytosol, bud neck50.151.18No -
C’ GFP library in SD+H2O2

cytosolN/AN/ANo -
C’ GFP library in Starvation Media

punctateN/AN/AYes -
C’ GFP library on the background of Pup2-DaMP

cytosol, bud neck -
C’ GFP library on the background of CCT mutant

cytosol, bud neck44.99311.06673No
